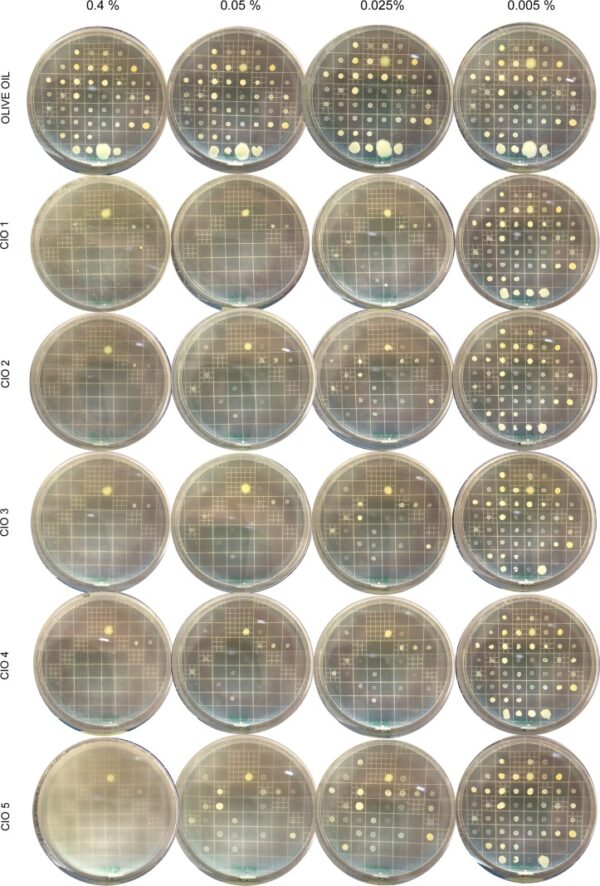

Dầu Mù U Ép Lạnh Tamanu Oil- Thần Dược Của Làn Da
Không phải ngẫu nhiên mà dầu mù u ép lạnh (mà ngày nay hay được người trẻ nhắc tới với tên gọi là virgin tamanu oil) được xem là thần dược của làn da.
Bài viết cung cấp kiến thức về cây dầu mù u cũng như tác dụng tuyệt vời đã được sử dụng lâu đời trong y học đông y cũng như khoa học hiện đại chứng minh bằng nhiều nghiên cứu uy tín.
Thông Tin Cơ Bản Về Cây Mù U
Cây mù u tên tiếng anh là tamanu , hoặc hay nhiều nơi còn gọi là mastwood, pannay tree .
Tên khoa học của mù u là: Calophyllum inophyllum.
Họ: Măng cụt (Guttiferae)
Cây mù u là cây mọc phổ biến ở khí hậu nhiệt đới, mọc nhiều ở các vùng nước Đông Nam Á. Ở Việt Nam, mù u chủ yếu phân bố ở vùng núi thấp, thuộc các tỉnh miền Trung, Đông và Tây Nam Bộ. Cây có thể mọc dọc theo các bờ kênh, rạch cao. Cây ra hoa nhiều mỗi năm, tái sinh tự nhiên chủ yếu từ hạt.
Cây mù u rất hữu ích, gỗ mù u rất cứng, chống mối lọt , chống thấm nước rất tốt nên thường dùng để làm tàu bè thuyền.
Lá của mù u rất đẹp, dày xanh mướt mịn.
Hoa thì rất nhiều, trắng muốt đẹp lãng mạn.
Quả mù u có nhân cứng màu xanh, rất tròn, có đường kính 2–3 cm và có một hạt. Quả khi chín chuyển sang màu vàng hoặc đỏ nâu. Bên ngoài quả thịt có vị ngọt, thơm ăn được. Bên trong hạt được bọc bởi cái gáo rất cứng, bên trong gáo là cái nhân hạt mù u.

Nhân chứa lượng dầu mù u rất lớn chiếm 45-52% trong hạt.
Thành Phần Của Dầu Mù U Ép Lạnh
Dầu mù u tên tiếng anh là tamanu oil hay calophyllum inophyllum oil (CIO) vaf virgin tamanu oil là dầu mù u ép lạnh nguyên chất.
Dầu mù u ép lạnh là dầu được ép từ nhân tươi của hạt mù u (bộ phận chứa dầu mù u ép lạnh ). Là loại dầu rất quen thuộc với thế hệ 8x trở về xưa . Còn các bạn trẻ thì lại biết tới dầu mù u là tamanu oil . Bởi vì nhờ vào các tinh năng tuyệt vời đối với chữa trị các bệnh về về da, các bện ngoài da và trong làm đẹp da
Dầu mù u có chất lượng tốt nhất phải là dầu mù u ép lạnh ép nguyên chất từ nhân hạt mù u tươi và quả mù u phải được chín. Chất lượng phụ thuộc vào sự am hiểu cũng như tỉ mỉ cẩn thận trâu chuốt của nhà ép dầu rất lớn.

Tỉ lệ axit béo trong dầu mù u
Tỉ lệ chất axit béo trong dầu mù u ép lạnh từ hạt tươi như sau:
Linoleic acid 31% (hay còn gọi là omega 3 )
Oleic acid 39% (hay còn gọi là omega 9 )
Stearic acid 13% (siêu phẩm dưỡng da )
Palmitic acid 14% (siêu phẩm phục hồi da )
Các thành phần khác
Các thành phần khác gồm calophyllolide, friedelin, inophyllums B & P, terpenic essences, benzoic & oxibenzoic acids, phospho-amino lipids, glycerides, saturated fatty acids, 4-phenylcoumarins. Các sản phẩm có chất lượng cao không chứa chì, không chứa thủy ngân, không chứa asen.
Lí Giải Tác Dụng Chữa Lành Da Của Dầu Mù U Từ Các Nghiên Cứu Khoa Học
Dầu mù u ép lạnh được khuyên dùng cho tất cả các loại bỏng, vết thương sau phẫu thuật giúp làm lành vết thương. Ngoài ra phải kể đến bệnh da liễu, mụn trứng cá, bệnh vẩy nến, mụn rộp, bệnh thấp khớp và bệnh lậu.
Trung tâm Thông tin Công nghệ sinh học Quốc gia – tiếng Anh là National Center for Biotechnology Information (viết tắt NCBI) là một đơn vị trực thuộc Thư viện Y học Quốc gia Hoa Kỳ, trực thuộc Viện Y tế Quốc gia Hoa Kỳ đã có đăng 1 nghiên cứu về dầu mù u vào ngày 05 tháng 9 năm 2015.
Phát hiện trong quá trình nghiên cứu
Vết thương mãn tính vẫn là một vấn đề nghiêm trọng đối với việc chăm sóc sức khỏe, đặc biệt là ở các khu vực nhiệt đới, nơi nhiệt độ và độ ẩm cao thúc đẩy nhiễm trùng vi khuẩn vết thương.
Sự gia tăng khả năng đề kháng của vi khuẩn đối với các loại kháng sinh hiện có và khả năng tiếp cận kém với các phương pháp điều trị làm trầm trọng thêm vấn đề này. Nhóm nghiên cứu đã nỗ lực để tìm ra các loại kháng sinh mới, dễ sản xuất tại địa phương và đến từ các nguồn rẻ và có thể tái tạo.
Từ đó nhóm nghiên cứu phát hiện ra dầu mù u, được mọc nhiều ở vùng Đông Nam Á giúp xử lý các vấn đề nan giải trong chữa trị vết thương.
Kích thích khả năng phòng vệ miễn dịch bẩm sinh.

Cũng cùng bài nghiên cứu của NCBI, dầu mù u ép lạnh chứa axit palmitic và axit oleic, cả hai đều được biết là làm tăng sản xuất và giải phóng β-defensin .
Các thành phần axit béo có thể có một vai trò khác không chỉ là tá dược tự nhiên của các thành phần hoạt tính sinh học mà còn bằng cách kích thích β-defensin.
β-defensin 2 là một peptide kháng khuẩn có liên quan đến khả năng miễn dịch của da ban đầu được phân lập từ da bị vảy nến.
Ngăn hấp thụ tia cực tím và chống oxy hóa
Dầu mù u có đặc tính ngăn hấp thụ tia cực tím và chống ôxy hoá. Kết hợp các đặc tính kháng sinh và chữa lành vết thương. Nó trở thành một ứng cử viên sáng giá trong chiến lược tìm phương pháp điều trị thay thế để điều trị các vết thương bị nhiễm trùng, đặc biệt là ở các khu vực nhiệt đới.
Chống lại vi khuẩn trong mụn trứng cá
Loại dầu cũng chống lại vi khuẩn Propionibacterium acnes và Propionibacterium granulosum, cả hai đều liên quan đến mụn trứng cá.
Mụn trứng cá là một trong những bệnh ngoài da phổ biến nhất, ảnh hưởng đến hơn 45 triệu người ở Hoa Kỳ. Người ta ước tính rằng gần 20 phần trăm tất cả các lần đến gặp bác sĩ da liễu có liên quan đến việc điều trị mụn trứng cá.
Chống lại các vi khuẩn đa kháng thuốc liên quan đến nhiễm trùng da.
Trong những năm gần đây, cộng đồng khoa học nhấn mạnh rằng việc phát triển thuốc kháng khuẩn không đủ để giải quyết các vấn đề do vi khuẩn gây bệnh đề kháng với kháng sinh. Và dầu mù u có khả năng chống lại các vi khuẩn đa kháng thuốc liên quan đến nhiễm trùng da.
Hình thể hiện dầu mù u kháng khuẩn tụ cầu vàng là một loài tụ cầu khuẩn vàng (vi khuẩn Staphylococcus aureus) Gram-dương hiếu khí tùy nghi, và là nguyên nhân thông thường nhất gây ra nhiễm khuẩn trong các loài tụ cầu. Nó là một phần của hệ vi sinh vật sống thường trú ở da được tìm thấy ở cả mũi và da.
Tụ cầu có thể gây ra rất nhiều bệnh nhiễm trùng khác nhau. Triệu chứng điển hình của nhiễm tụ cầu trên da là bệnh chốc lở và hình thành những ổ áp-xe chứa đầy mủ, sưng đau và tấy đỏ, và thường là kèm theo chảy mủ. Nếu tụ cầu xâm nhập vào máu (gây nhiễm khuẩn huyết), các triệu chứng sẽ bao gồm sốt, ớn lạnh và hạ huyết áp.
Những phụ nữ cho con bú có thể bị nhiễm một bệnh do tụ cầu gọi là chứng viêm vú, có thể đưa vi khuẩn vào sữa mẹ. Tụ cầu phải khi xâm nhập vào phổi có thể gây viêm phổi, khi vào xương nó có thể gây viêm tủy xương. Nhiễm khuẩn huyết do tụ cầu vàng cũng có thể gây nhiễm trùng ở tim và van tim.
Nếu tụ cầu lưu thông trong máu, nó có thể được chuyển đến các hệ cơ quan trong cơ thể và gây các bệnh nhiễm trùng nghiêm trọng, có thể nguy hiểm đến tính mạng (nhiễm khuẩn huyết), có thể dẫn tới sốc hay suy đa phủ tạng và gây tử vong.
Công Dụng Tuyệt Vời Của Dầu Mù U Trong Y Học Cổ Truyền
Các công dụng dưới đây dựa vào y học cổ truyền lưu truyền trong dân gian đồng thời dựa vào nghiên cứu khoa học mà chúng tôi lượt dịch bên trên.
Dầu mù u ép lạnh trị mụn:
Ngay lập tức giảm nhẹ các biểu hiện sưng tấy, nóng đỏ khi nổi mụn, tiêu biến nhân mụn, xóa mờ vết thâm sau mụn. Đó là những công dụng trị mụn toàn diện khiến dầu mù u ép lạnh trở thành sản phẩm trị mụn không thể thiếu của các nàng da dễ mụn không chỉ ở Việt Nam mà đây còn là sản phẩm làm đẹp được chị em Nhật, EU hay Mỹ ,Hàn săn lùng.
Cách sử dụng trong trị mụn :
- Rửa mặt sạch bằng nước hoặc bằng xà bông tự nhiên sau đó đổ dầu ép lạnh ra tay và xoa nhiều vào vùng da có mụn, xoa chỗ cái mụn và lan ra xung quanh mụn.
- Pha dầu mù u ép lạnh vào với dầu mè đen ép lạnh, hãy lắc đều rồi đổ lượng dầu này ra ướt đẫm đầy 1 bàn tay.
- Xoa 2 lòng bàn tay vào nhau cho ấm hỗn hợp dầu này lên rồi massage xa nhẹ nhàng từ 5-15 phút trên toàn mặt hoặc toàn thân hoặc toàn lưng nơi có mụn cho dầu thấm sâu rồi nhúng khăn xô vào nước ấm lau sạch mặt lại rồi khoát nước lạnh rửa lại cho sạch.
- Xoa thêm 1 lớp dầu mù u ép lạnh nguyên chất trực tiếp như cách 1 trên. Hiệu quả bất ngờ.
Những da có mụn nhọt , mụn bọc, mọn sưng , mụn trứng cá bôi trực tiếp lên ngày 2-3 lần sẽ làm khô mụn và bay mờ vết thâm mụn.
Điều trị các bệnh viêm nhiễm về da :
Sản phẩm chuyên dùng để điều trị các bệnh viêm nhiễm về da như: hăm tả, chàm đỏ ở trẻ sơ sinh trẻ nhỏ, viêm da , ghẻ, chốc lở, mẩn ngứa, nấm da chân, nấm toàn thân, vẩy nến, viêm loét nhiễm trùng, nặng hơn có thể là hoại tử da, các vết rách do da bị trầy xước té ngã. Thậm chí là các bệnh nặng như á sừng.
Dầu mù u ép lạnh cũng làm lành các vết thương do nước ăn chân, nấm chân gây ra do nước nhiễm bẩn.
Dầu mù u ép lạnh trị bỏng :
Ngoài ra, vết bỏng sau khi được bôi dầu mù u ép lạnh thường xuyên sẽ chóng lành, không bị phỏng rộp mà không để lại sẹo trên da.
Tái tạo da, tăng sinh tế bào và kích thích sản xuất các thành phần quan trọng như collagen, glycosaminoglycan,… đều là những yếu tố tạo nên tác dụng chữa sẹo nhanh chóng của sản phẩm này.
Cách sử dụng trong trị bỏng
Bước 1: Nếu không may bị bỏng, bạn nên nhanh chóng hạ nhiệt vết bỏng bằng cách sơ cứu, làm mát vết bỏng với nước lạnh, thực hiện trong vòng 5 phút sau khi bỏng. Vết thương nhanh chóng được làm dịu đi và dễ điều trị hơn.
Bước 2: Rửa sạch vết bỏng bằng nước sạch, để rửa trôi chất bẩn và rửa trôi vi khuẩn tấn công.
Bước 3: Tiếp theo, đổ đẫm dầu lên vết bỏng . Để phát huy tác dụng, mỗi ngày hãy dùng đều đặn từ 3-5 lần cho đến khi vết bỏng lành hẳn. Ngoài ra sau khi vết bỏng đã lên da non và cải thiện rồi,bạn vẫn có thể thường xuyên sử dụng dầu mù u ép lạnh để giảm kích thước sẹo do vết bỏng để lại. Có thể dùng tương tự đối với những vùng da để lại sẹo khác.
Sau khi rửa sạch vết thương bằng nước sạch : bôi trực tiếp dầu mù u ép lạnh lên vùng da tổn thương, dầu mù u ép lạnh có tính kháng khuẩn và làm lành vết thương nhanh chóng.
Tuỳ vết thương to nhỏ sẽ lành sau 3-9 tuần sử dụng dầu mù u và không để lại sẹo.
Sử dụng làm đẹp, dưỡng da
Ngoài tác dụng điều trị hiệu quả các bệnh lý viêm nhiễm da kháng khuẩn , dầu mù u ép lạnh còn là sản phẩm làm đẹp được khuyên dùng. Có lẽ ít ai biết, sản có khả năng chống tia cực tím cực mạnh, tương đương chỉ số chống nắng SPF 20.
Vừa là màng bảo vệ tối ưu cho da khỏi những tác nhân có hại từ ánh nắng mặt trời, sản phẩm còn giúp làn da cải thiện nhanh với các thương tổn do cháy nắng như giảm thâm nám, xóa các vết sạm da, đưa làn da trở về da bình thường khỏe mạnh.
Ngoài ra, với tác dụng cân bằng độ ẩm tốt cho da, dầu mù u ép lạnh còn khiến làn da của bạn trở nên mềm mại, căng bóng mịn màng.
Điều này cũng có nghĩa dầu mù u ép lạnh chống lão hóa hiệu quả.
Cách sử dụng trong liệu pháp dưỡng da bằng dầu
Pha dầu mù u ép lạnh vào với dầu mè đen ép lạnh hoặc dầu sacha inchi ép lạnh hoặc bất kỳ dầu ép lạnh nào phù hợp với thể trạng của bạn. Hãy điều chỉnh tỉ lệ cho phù hợp với da của chính bạn.
Thường thì bạn phải tự điều chỉnh tuy nhiên lời khuyên của chúng tôi cho làn da thường muốn dưỡng mịn, mướt, căng bóng, và khỏe mạnh là tỉ lệ 10%.
Tuy nhiên bạn hãy thử thêm bớt tùy trải nghiệm và tương thích với làn da. Hãy lắc đều hỗn hợp dầu này, rồi đổ đẫm dầu đầy 1 bàn tay, xoa 2 lòng bàn tay vào nhau cho ấm hỗn hợp dầu này lên rồi massage xa nhẹ nhàng từ 5-30 phút trên toàn bộ vùng da cho dầu thấm sâu rồi nhúng khăn xô vào nước ấm lau sạch mặt lại rồi khoát nước lạnh rửa lại cho sạch.
Sau đó xoa thêm 1 lớp dầu này lên da thật mỏng trước khi ngủ hoặc trước khi make up
Dầu mù u ép lạnh dưỡng tóc, trị gàu
Dầu mù u ép lạnh có khả năng làm sạch da đầu, làm sạch gàu cho tính năng kháng nấm gàu da đầu. Giúp chân tóc thông thoáng , giúp da đầu cân bằng sạch sẽ, giúp phần tóc mọc ra mới đẹp mướt óng ả. Đối với những tóc đã bị hư tổn, các tỉ lệ axit béo sẽ hàn gắn phần xơ thô ráp của tóc, cung cấp những dưỡng chất thiết yếu cho tóc, giúp tóc trông mượt mà suôn mềm óng ả.
Cách sử dụng dầu mù cho tóc :
Hãy xịt trực tiếp sản vào da đầu. Ủ lại trên 1h càng lâu càng tốt. Sau đó gội lại bằng xà bông tự nhiên, có thể xả lại tóc bằng 1 ít nước cốt chanh tùy độ dài của tóc mà 1 -3 trái chanh.
Chữa zona hay chữa giời leo cực kì hiệu quả :
Đỗ đẫm dầu mù u ép lạnh trực tiếp lên khắp nơi có vết bỏng của zona giời leo , sẽ ngay lập tức giảm đau nhứt vết bỏng zona , tiếp theo là làm khô vết bỏng zona và hạn chế tối da bị sẹo do zona.
Làm hết ngứa do côn trùng
Gồm các loại côn trùng như muỗi, sâu bọ, kiến , hay dịch độc của kiến ba khoang kể cả đối với trẻ nhỏ. Đổ trực tiếp dầu mù u ép lạnh lên vết côn trùng cắn sẽ ngăn ngừa nhiễm trùng, giảm ngứa ngay lập tức. Dầu mù u ép lạnh KHÔNG phù hợp với các con vật có nộc độc như rắn.
Dầu mù u ép lạnh chữa trĩ
Với việc sử dụng dầu mù u ép lạnh, những người mắc bệnh trĩ sẽ có một giải pháp hữu hiệu cho những khó khăn mà họ gặp phải. Sản phẩm bên cạnh tác dụng giảm các cơn đau gây ra bởi trĩ mà còn làm teo các búi trĩ.
Cách sử dụng trong chữa trĩ
Bạn có thể bôi trực tiếp dầu mù u ép lạnh lên vùng hậu môn.
Để thực hiện việc này thì trước đó bạn cần đeo găng tay sạch và vệ sinh vùng hậu môn có búi trĩ một cách sạch sẽ.
Rồi tiếp theo mới cho dầu mù u lên đầu ngón tay và thoa vào vùng bị đau do trĩ.
Tài liệu tham khảo cho bài viết :
https://online.personalcarecouncil.org/jsp/CIRList.jsp?id=388
https://en.wikipedia.org/wiki/Tamanu_oil
https://www.ncbi.nlm.nih.gov/pmc/articles/PMC4583440/#pone.0138602.s007
https://hellobacsi.com/da-lieu/cham-soc-da/cong-dung-cua-dau-mu-u/
https://www.ncbi.nlm.nih.gov/core/lw/2.0/html/tileshop_pmc/tileshop_pmc_inline.html?title=Click%20on%20image%20to%20zoom&p=PMC3&id=4583440_pone.0138602.g002.jpg
https://www.sciencedirect.com/topics/pharmacology-toxicology-and-pharmaceutical-science/stearate
https://journals.sagepub.com/doi/pdf/10.3109/10915818709098563
https://www.ncbi.nlm.nih.gov/pmc/articles/PMC6928966/
https://pubchem.ncbi.nlm.nih.gov/compound/Palmitic-acid#section=LC-MS
https://www.ncbi.nlm.nih.gov/pmc/articles/PMC5796020/
Bài Viết: bởi NOOMFOOD


0983569749
Viết bình luận